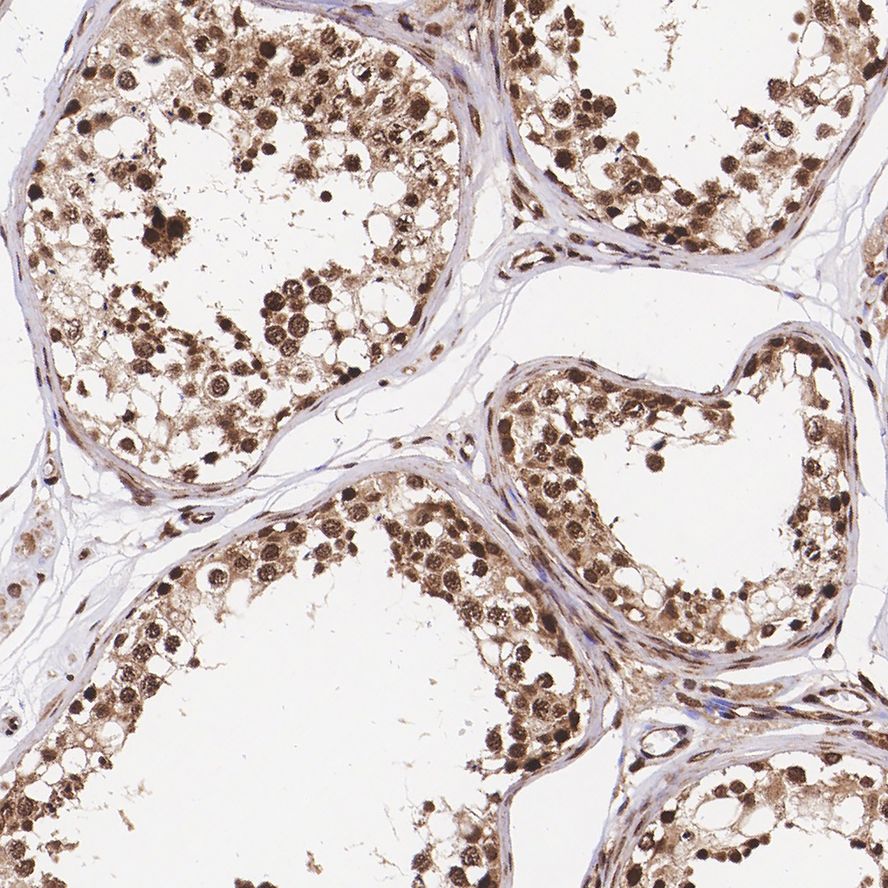

Lin28A Rabbit Monoclonal Antibody(ARA838)
CAT.NO. : ARA6653
RMB Please choose
RMB Please choose
Size:
Trail, Bulk size or Custom requests Please contact us
Background
LIN-28 is a highly conserved, RNA-binding, cytoplasmic protein. It consists of a cold shock domain and retroviral-type (CCHC) zinc finger motifs that were first identified in Caenorhabditis elegans. LIN-28 controls the timing of events during embryonic development and is readily expressed in embryos, embryonic stem cells and embryonal carcinoma cells. The presence of LIN-28 persists in some adult tissues including cardiac and skeletal muscle. In differentiating myoblasts, LIN-28 increases protein sysnthesis efficiency and binds to the growth and differentiation factor IGF-II.
Overview
|
Product Name |
Lin28A Recombinant Rabbit Monoclonal Antibody (ARA838) |
|
Antibody Type |
Recombinant Rabbit monoclonal Antibody |
|
Immunogen |
Synthetic peptide within Human Lin 28A aa 10-59 /200. |
|
Species Reactivity |
Human, Mouse, Rat |
|
Validated Applications |
WB, IHC-P |
|
Molecular Weight |
Predicted band size: 23 kDa |
|
Positive Control |
NCCIT cell lysates, JAR cell lysate, human testis tissue, mouse placenta tissue, rat testis tissue. |
|
Conjugation |
unconjugated |
Application
|
Application |
Dilution Ratio |
|
WB |
1:800-1:1,000 |
|
IHC-P |
1:400-1:1,000 |
Data

Western blot analysis of Lin28A on NCCIT cell lysates with Rabbit anti-Lin28A antibody (ARA838) at 1/1,000 dilution.

Immunohistochemical analysis of paraffin-embedded human testis tissue with Rabbit anti-Lin28A antibody (ARA838) at 1/1,000 dilution.

Immunohistochemical analysis of paraffin-embedded mouse placenta tissue with Rabbit anti-Lin28A antibody (ARA838) at 1/1,000 dilution.

Immunohistochemical analysis of paraffin-embedded rat testis tissue with Rabbit anti-Lin28A antibody (ARA838) at 1/400 dilution.
Storage
Store at 4°C short term. For long term storage, store at -20°C, avoiding freeze/thaw cycles.
Research Use Only
For Research Use Only. Not for use in diagnostic procedures.
 New Products
New Products